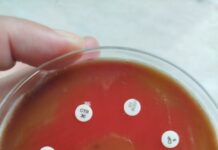
Бактерия човекоядец

A cancer patient was outraged by medical incompetence in a Burgas hospital. The victim contacted Iskra.bg after a follow-up ultrasound examination at the Complex Oncology Center-Burgas. He was puzzled by the results – they found a cyst on his kidney, which was removed in December 2022.
The patient requested anonymity due to his condition and further medical procedures to come, and we will not mention his name in the article. He narrated:
“I was diagnosed with cancer a few years ago, and for that I have to go for check-ups every three months. The first time I went they did blood tests and sent me to an ultrasound where a young guy was working. In my opinion, it is not that competent in its field. Then I asked him if he saw anything worrisome and he replied that for my diagnosis something would best show up on the nuclear magnetic resonance and scanner, but the Health Insurance Fund only covers the tumor markers and the ultrasound.”
According to the patient, these examinations do not show specific results, but are meant to drain the National Health Insurance Fund. The reason for his conclusions are:
“A few months ago I had my right kidney removed. At that time I was at 40% vital signs and they operated on me, although they did not give me a chance to live. I couldn’t go through the National Health Service for an examination then in Onkoto.”
“The last time I went to the Medical Center, they asked me where my examination from the previous sonographer was, and I explained that I had not passed it. They told me that in case of a possible inspection by the Health Insurance Fund, it would create a problem for them. These reviews are free anyway. I go for an ultrasound and there was this young man again. After the examination, I asked him if everything was okay, to which he again replied: “I don’t know if I told you, but for your disease, the ultrasound does not really matter”, the patient said. He continued:
“When I left the office, I started to read what the result was – left kidney normal, right kidney a cyst was found 4 millimeters to the right.”
The paradox here is that the patient does not have a right kidney. He sent us an epicrisis, where it is stated that the organ was removed.
“How did they see him as a right-winger when he wasn’t there?“ If only they had said in some body that exists, not in a abolished one. For me, each patient’s previous tests are stored in the device and the same ones are run each time to report activity. I went back and asked the operator, “How did you find my cyst when I don’t have a kidney?” and he said, “That’s what I told you, did you see how much work the sonographer is doing for you.” I went up to the register to I left the tests and asked: „How do you find a cyst when I don’t have an organ?“, there was no answer,” the victim expressed his indignation.
The patient wonders how a medical professional could not see that an organ was missing.
Here comes a few questions:
- – Are the specialists appointed in our health facilities competent in reading research?
- – How can patients trust a medical professional when they may be misdiagnosed?
- – Who monitors such irregularities and misdiagnoses?
- – Where can patients seek their rights in such situations?
- – Are there any medical specialists left in Bulgaria who can provide quality treatment?
Medical malpractice is defined as an incorrect action or omission or a combination of such by a medical professional. This can have a negative impact on the patient’s health.
From Iskra.bg, we remain open for all parties involved in the case to speak.